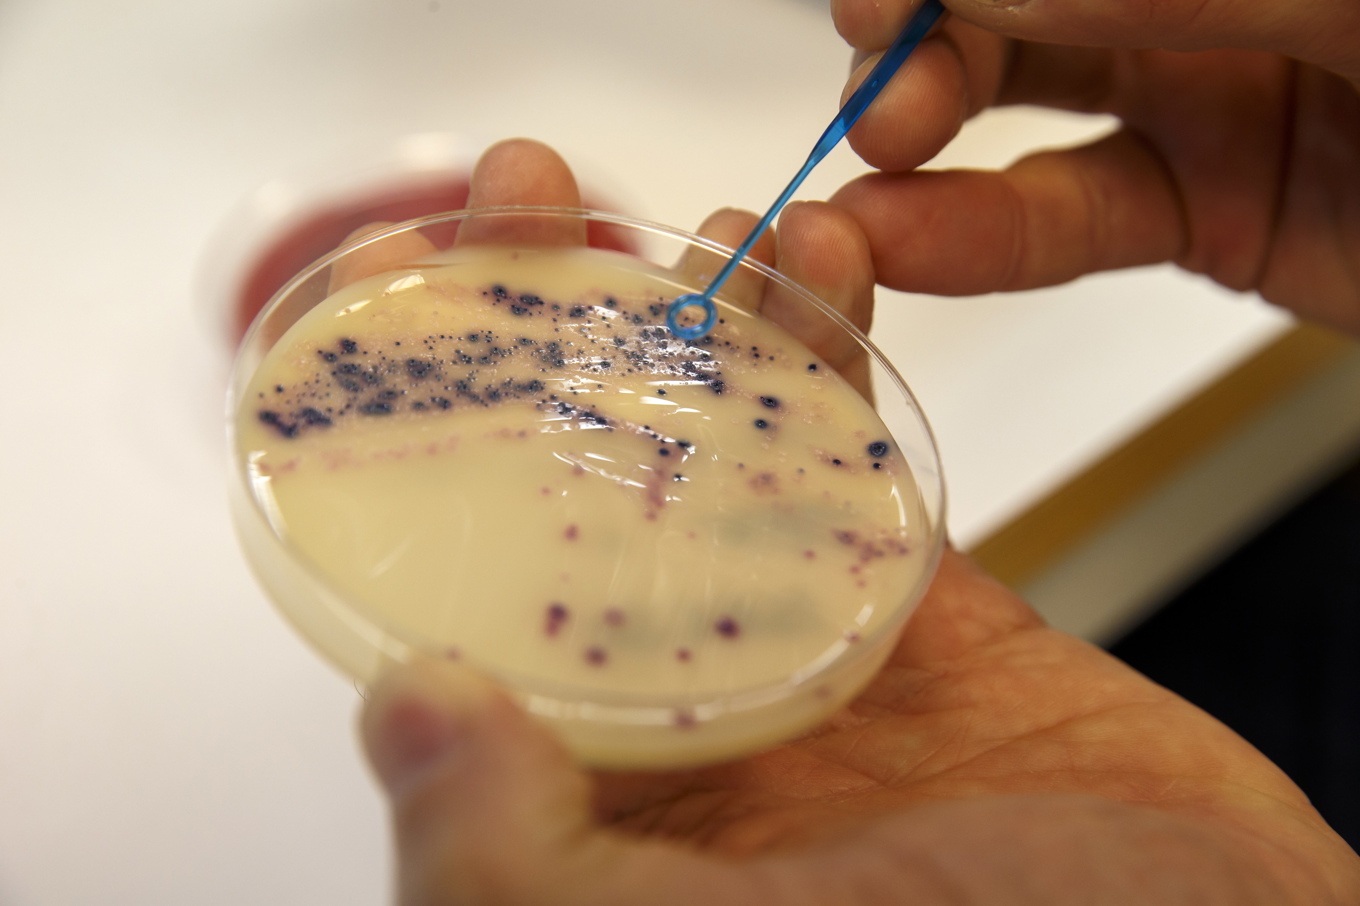
Antibiotikaresistens är ett växande problem världen över. Nanoplaster i våra kroppar kan göra det värre. Arkivbild. Foto: Cornelius Poppe/NTB/TT

Nanoplast, plastfragment så små att de inte syns med blotta ögat, kan ta sig in i våra kroppar och göra oss sjuka. Men det finns också en risk för att de hindrar oss från att bli friska.
– Det finns ett talesätt som säger att om två problem löper längs samma tidslinje kan de ha negativ inverkan på varandra även om de inte hänger ihop, säger Nikola Zlatkov Kolev, forskare vid Institutionen för molekylärbiologi vid Umeå universitet.
Vår användning av plast respektive antibiotika har länge löpt parallellt. En studie som letts från Umeå universitet visar att nanoplaster som kommer in i kroppen kan försämra effekten av antibiotika.
– Vad vi står inför nu är två stora problem som smälter ihop med varandra.
Nanoplaster är plastpartiklar som är mindre än en tusendels millimeter. De kan sväva fritt i luften och ta sig in i kroppen.
Forskarna tittade på hur några av de vanligaste nanoplasterna interagerade med antibiotikan tetracyklin och kunde konstatera att plasten suger åt sig antibiotikan.
– Tetracyklinet var bundet till plasten och kunde därför inte döda bakterierna, säger Nikola Zlatkov Kolev, som ledde delstudien om bindningen till antibiotika.
Tetracyklin är en antibiotika som används främst mot olika allvarliga luftvägssjukdomar.
Bindningen var särskilt stark till nanopartiklar av nylon, ett av de ämnen som är vanligast i nanoplasterna i inomhusluften.
Det finns en risk för att det kan leda till att antibiotikan följer med nanoplasten i blodomloppet och hamnar på fel ställen i kroppen. Det i sin tur kan minska antibiotikans riktade effekt och göra så att antibiotikaresistenta bakterier uppstår, en utveckling forskarna ser som mycket oroande.
– I grund och botten står vi inför en ny sorts resistens.